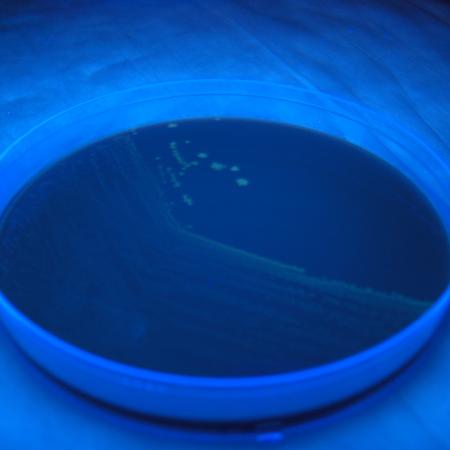
Laboratory Developed Tests Search Tool

How can the New York State Department of Health Clinical Laboratory Evaluation Program help you today?
Certificate of Qualification (CQ) Applications
Lab Developed Test (LDT) Approval
On-Site Survey Process / Facility Personnel Form (FPF)
If you need assistance with something else, we encourage you to use the purple menu to the right, or contact the program with a concern.
Program Updates
The Single Use Lab Permit application process is live
The Single Use Permit process has replaced the Non-Permitted Laboratory request process. Applications for a Single Use Permit must be submitted by the TESTING LABORATORY using eCLEP. We will no longer accept requests from the REFERRING ENTITY.Please refer to the new Single Use Permit webpage for more information.
READ MORE about The Single Use Lab Permit application process is live Wadsworth Center Scientist Contributes to International Standards for Clinical Laboratories
The Clinical Laboratory Evaluation Program (CLEP) within the Wadsworth Center regulates clinical laboratory testing in New York State. Among its regulatory responsibilities, CLEP is currently the only regulatory agency in the United States that conducts formal review of Laboratory Developed Tests (LDTs). While clinical laboratories outside New York State may develop and use LDTs without FDA approval, any laboratory seeking to test New York State specimens must obtain CLEP approval.
READ MORE about Wadsworth Center Scientist Contributes to International Standards for Clinical Laboratories Clarification on Clinical Laboratory Testing Personnel Requirements; glucometry
Click here for Clarification on Clinical Laboratory Testing Personnel Requirements; glucometry
READ MORE about Clarification on Clinical Laboratory Testing Personnel Requirements; glucometry Proposed Regulations open for Public Comment
Proposed regulations to amend Subpart 58-1 and the addition of Subpart 58-6 to replace Part 19 are available for public comment at
READ MORE about Proposed Regulations open for Public Comment Wadsworth Center Creates Path for Hospital-at-Home and Clinical Testing in New York State
The Clinical Laboratory Evaluation Program (CLEP) within the Wadsworth Center has taken an important step to support the expansion of Hospital at Home (HaH) services in New York State. CLEP, which has regulatory oversight authority for all clinical laboratories under Article 5, Title 5 of the New York State Public Health Law (PHL), ensures that any facility performing tests on human-derived materials meets state standards for quality and safety. This authority applies not only to hospital-based laboratories but wherever testing is performed – including at home.
READ MORE about Wadsworth Center Creates Path for Hospital-at-Home and Clinical Testing in New York State Revised Remote Activities Policy
Click here for the October 2025 revision to the remote activities policy.
READ MORE about Revised Remote Activities Policy Wadsworth Center Leadership Featured at BBANYS Annual Meeting
Ms. Beverly Rauch, Clinical Laboratory Evaluation Program (CLEP) Director at the NYS DOH’s Wadsworth Center, delivered a featured presentation at the 2025 Annual Meeting of the Blood Banks Association of New York (BBANYS).
READ MORE about Wadsworth Center Leadership Featured at BBANYS Annual Meeting An Interview with Beverly Rauch: Regulating the Safety and Effectiveness of Clinical Laboratory Testing
Beverly Rauch, Deputy Director of the Division of Laboratory Quality Certification and Director of the Clinical Laboratory Evaluation Program (CLEP) was a guest on LabMind, an ARUP Laboratories’ education department podcast. Beverly described the history of the NYS CLEP program and discussed how CLEP provides regulatory oversight of clinical laboratories.Click here to read more and listen to the podcast.
READ MORE about An Interview with Beverly Rauch: Regulating the Safety and Effectiveness of Clinical Laboratory Testing Test Approval
Only laboratories that hold a New York State clinical laboratory permit are authorized to perform testing on specimens originating from New York. Review of laboratory-developed tests (LDT) begins after the clinical laboratory permit application has been submitted. Please refer to our Obtain a Permit page. LDT review is not offered as a stand-alone service.
READ MORE about Test Approval CLEP Releases LDT Review Data
There is national interest in the Laboratory-Developed Test (LDT) review process implemented by the Clinical Laboratory Evaluation Program (CLEP) of the New York State Department of Health. CLEP has been reviewing LDTs since 1991. Our review process has changed over the years, but our current review policy is described in detail on our website https://www.wadsworth.org/regulatory/clep/clinical-labs/obtain-permit/test-approval.
Under the current policy, a committee of sub
READ MORE about CLEP Releases LDT Review Data Revised Standards are now available
Revisions to the New York State Clinical Laboratory Standards of Practice are now available, including:
Current Standards General Systems Standards Effective May 5th, 2021 Specialty Requirements by Category with Microbiology and Pathology Standards of Practice, effective May 2021
Standard Revisions
READ MORE about Revised Standards are now available New Tool to Search Laboratory Developed Tests
What can this tool do for me?
It can tell you which labs perform a certain test, the name of the labs and where they are located.
You can find tests performed within a given category for each approved lab and which sample type those tests can be performed on.
Explore the new laboratory developed test search tool.
READ MORE about New Tool to Search Laboratory Developed Tests CLEP Announces New PT Survey Search Tool
A new search tool is available to help laboratories find providers and products that meet NYS proficiency testing (PT) requirements for analytes described in 42 CFR Subparts H and/or I.
Laboratories are required to notify CLEP of their PT enrollment choices each year in the Fall and whenever adding a new analyte to the test menu that is described in CLIA subparts H and/or I.
READ MORE about CLEP Announces New PT Survey Search Tool